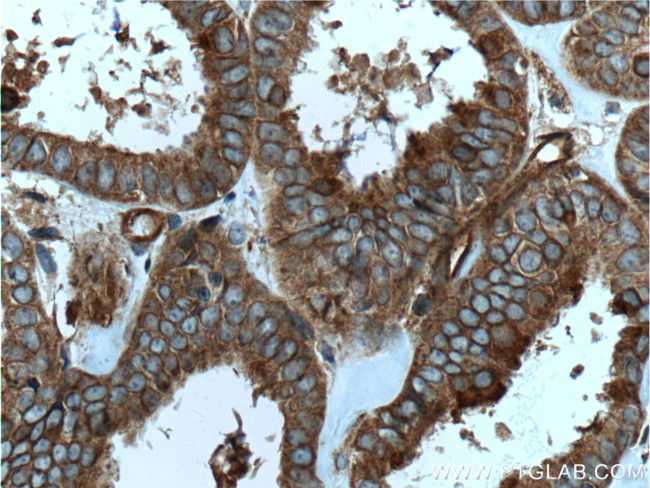
RALB Antibody in Immunohistochemistry (Paraffin) (IHC (P))
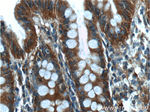
RALB Antibody in Immunohistochemistry (Paraffin) (IHC (P))

Search
Proteintech
RALB Polyclonal Antibody
{{$productOrderCtrl.translations['antibody.pdp.commerceCard.promotion.promotions']}}
{{$productOrderCtrl.translations['antibody.pdp.commerceCard.promotion.viewpromo']}}
{{$productOrderCtrl.translations['antibody.pdp.commerceCard.promotion.promocode']}}: {{promo.promoCode}} {{promo.promoTitle}} {{promo.promoDescription}}. {{$productOrderCtrl.translations['antibody.pdp.commerceCard.promotion.learnmore']}}
产品信息
12340-1-AP
种属反应
已发表种属
宿主/亚型
分类
类型
抗原
偶联物
形式
浓度
规格
纯化类型
保存液
内含物
保存条件
运输条件
产品详细信息
Immunogen sequence: MAANKSKGQ SSLALHKVIM VGSGGVGKSA LTLQFMYDEF VEDYEPTKAD SYRKKVVLDG EEVQIDILDT AGQEDYAAIR DNYFRSGEGF LLVFSITEHE SFTATAEFRE QILRVKAEED KIPLLVVGNK SDLEERRQVP VEEARSKAEE WGVQYVETSA KTRANVDKVF FDLMREIRTK KMSENKDKNG KKSSKNKKSF KERCCLL (1-206 aa encoded by BC018163)
靶标信息
This gene encodes a GTP-binding protein that belongs to the small GTPase superfamily and Ras family of proteins. GTP-binding proteins mediate the transmembrane signaling initiated by the occupancy of certain cell surface receptors.
仅用于科研。不用于诊断过程。未经明确授权不得转售。
生物信息学
蛋白别名: GTP binding protein; GTP-binding protein (RALB); OTTHUMP00000204385; OTTHUMP00000207264; RALB Ras like proto-oncogene B; ras related GTP binding protein B; RAS-like protein B; Ras-related protein Ral-B; small GTP binding protein; unnamed protein product; v-ral simian leukemia viral oncogene homolog B (ras related; GTP binding protein)
基因别名: 5730472O18Rik; RALB
UniProt ID: (Human) P11234, (Mouse) Q9JIW9
Entrez Gene ID: (Human) 5899, (Mouse) 64143